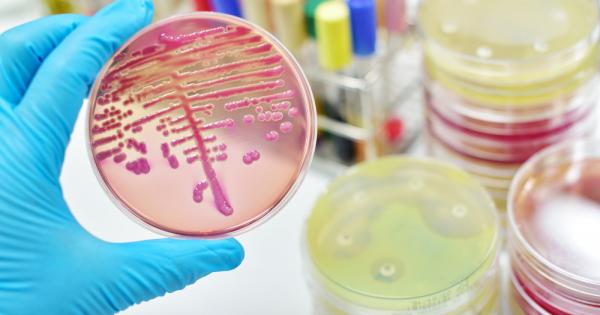
Докато учените работеха усилено за да намерят нови начини за

... бактериите от глад. Независимо от пътищата на борба, повече внимание и координация на услията е необходима за да се осигури успешно справяне със супер-бактериите. Източник: Science Alert
Супер Бактерии - Новини
Учени от университета Куин Мери в Лондон твърдят че Индия е потенциален инкубатор за супербактерии съобщават
...... в радиус от един метър и човек, който влезе в контакт със заразено животно, може да предаде заразата без каквито и да било явни симптоми.